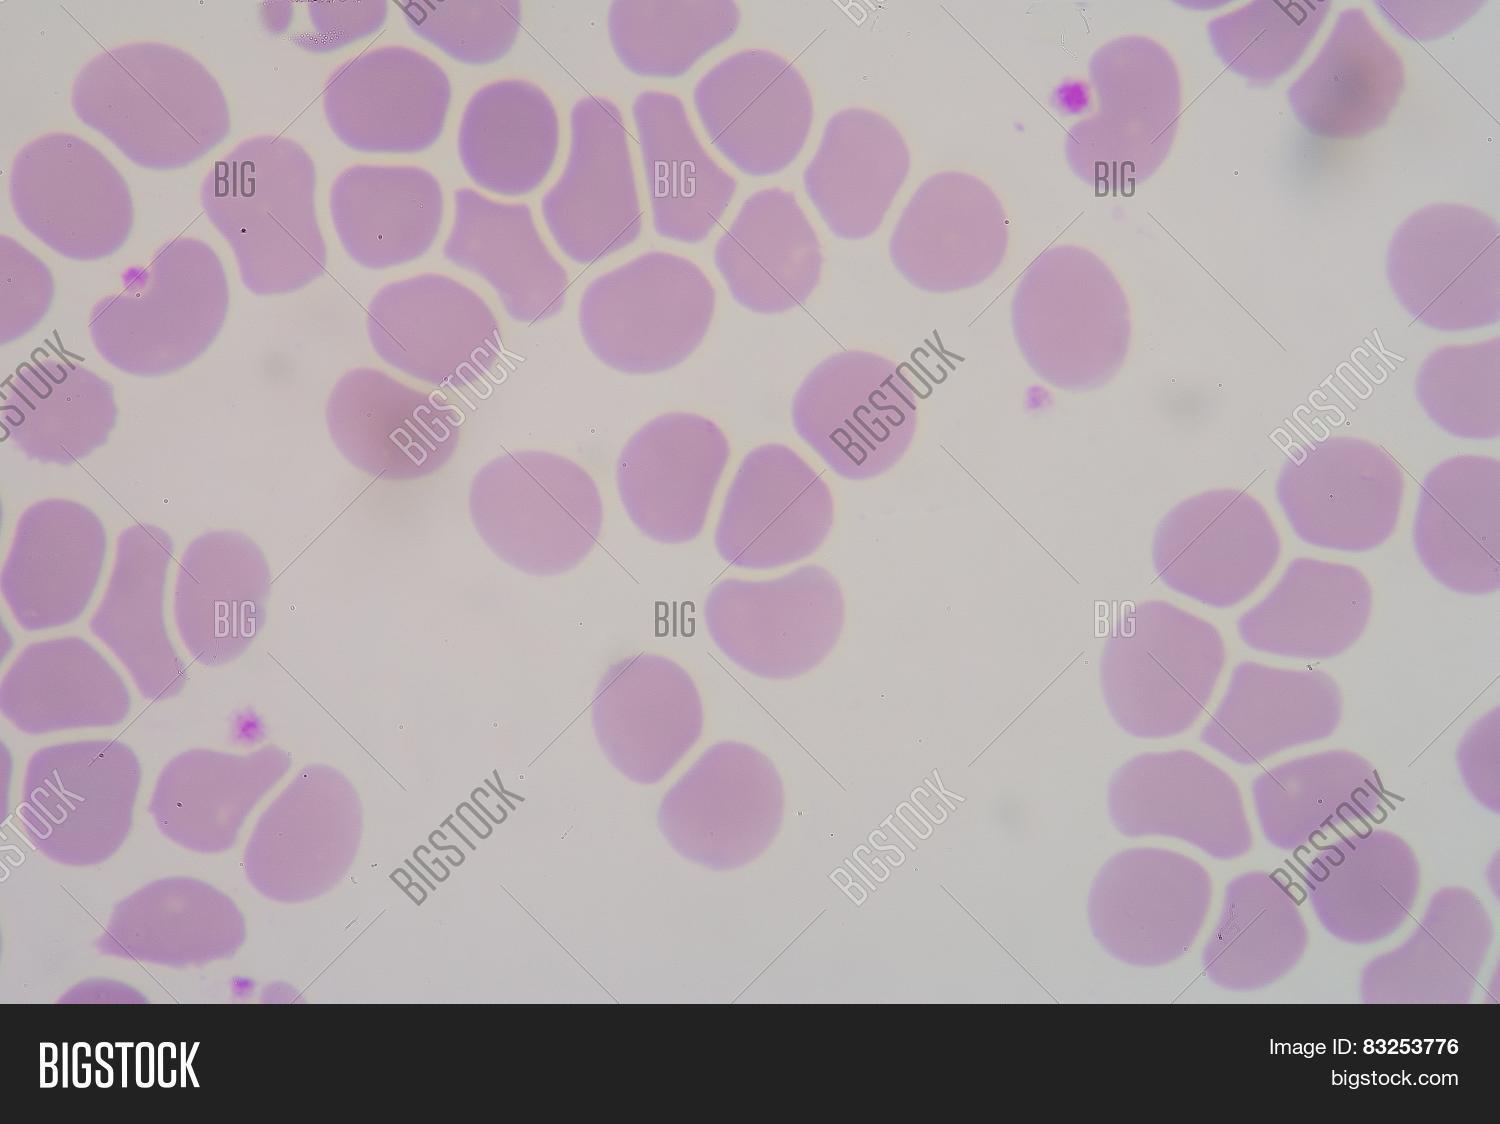
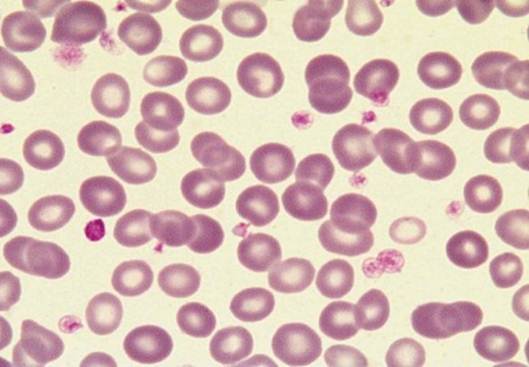

Микроцитоз и макроцитоз
Российский онкологический
Импортные пошлины оборудования
Iqoo 3
Котел не разгорается
Asus prime 5080 oc
Как попросить сделать репост
Cr2o3 степень окисления каждого
Что нужно для грузии россиянину
Русский язык 5 номер 453
Компендиум что это такое
Погода москва останкинский
Как правильно читать аят аль курси
0 градусов цельсия это сколько по фаренгейту
Микроцитоз и макроцитоз 111 фото